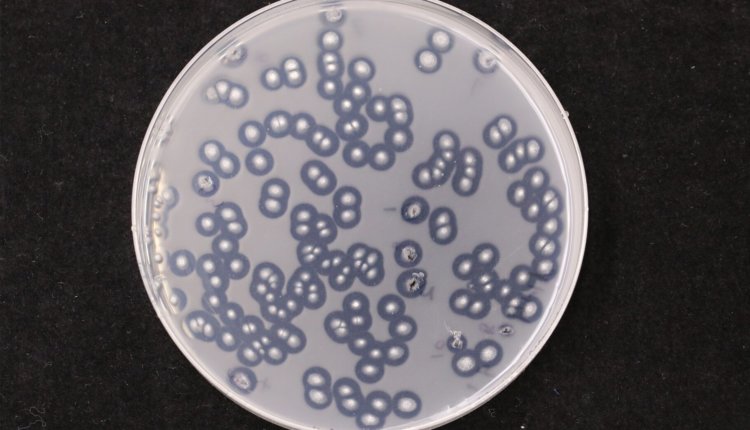

Ученые обнаружили «микробных супергероев», помогающих в борьбе с пластиковым загрязнением
В солончаках Цзянсу Китая обнаружены грибы и бактерии, разлагающие пластик
Международная команда ученых идентифицировала в прибрежных солончаках Цзянсу Китая в общей сложности 184 грибковых и 55 бактериальных штамма, способных расщеплять поликапролактон (PCL), биоразлагаемый полиэфир, обычно используемый в производстве различных полиуретанов. Примечательно, что штаммы бактерий, принадлежащие к родам Jonesia и Streptomyces, проявили потенциал к дальнейшему разложению других полимеров на основе нефти, будь то природных или синтетических.
Отбор проб, проведенный в мае 2021 года в Дафенге, охраняемом ЮНЕСКО месте недалеко от побережья Желтого моря, подтвердил существование наземной пластисферы — концепции, относительно новой для наземной экологии, поскольку предыдущие исследования в основном были сосредоточены на морской среде. Кроме того, микробиом, обнаруженный в этой «искусственной экологической нише» прибрежного пластикового мусора, продемонстрировал отличные характеристики по сравнению с окружающей почвой.
В связи с растущей глобальной озабоченностью по поводу загрязнения пластиком ученые все чаще обращаются за решениями к микроорганизмам, таким как грибы и бактерии. Программа ООН по окружающей среде (ЮНЕП) сообщает о ежегодном появлении 400 миллионов тонн пластиковых отходов, причем уровень загрязнения резко возрос с 1970-х годов. Однако исследователи надеются, что ответы на этот кризис кроются в пластисфере.
Предыдущие исследования уже выявили потенциал микроорганизмов в борьбе с пластиковыми отходами. В 2017 году китайские и пакистанские исследователи обнаружили штамм грибов Aspergillus tubingensis, расщепляющий пластик на свалке в Исламабаде. На сегодняшний день ученые выявили 436 видов грибов и бактерий, способных к разложению пластика. Последние открытия ученых из Королевского ботанического сада Кью (Лондон) и партнеров, опубликованные Исследование, опубликованные в Journal of Hazardous Materials, могут проложить путь к разработке эффективных ферментов, предназначенных для биологического расщепления пластиковых отходов.
— Мы не сомневаемся, что микробы найдут способы эффективно разлагать пластик, но на это могут уйти тысячи лет, если мы предоставим природе идти своим чередом, — отметила старший научный руководитель по разнообразию и систематике грибов в Кью доктор Ирина Дружинина. — Вот почему наша задача состоит в том, чтобы использовать знания, которыми мы уже обладаем в области биологии микроорганизмов, ускорить и направить эволюцию микробов и их отдельных генов таким образом, чтобы они выполняли свою работу сейчас.
Пластмассы в водных экосистемах создают «микробный риф» благодаря своей долговечности и гидрофобной поверхности, обеспечивая точки прикрепления грибков и бактерий. Биоразлагаемые пластики могут служить источником углерода для метаболизма микробов. В случае с Dafeng исследователи собрали 50 образцов пластиковых отходов из семи различных типов полимеров на нефтяной основе.
В ходе исследования было выявлено 14 родов грибов, включая патогены растений Fusarium и Neocosmospora. Интересно, что эти растительнопатогенные грибы проявили потенциал в разложении пластмасс PCL и других синтетических полимеров, превзойдя сапротрофные грибы, которые обычно питаются мертвыми растительными и животными останками.
Хотя результаты исследования многообещающи, авторы предупреждают, что наше понимание микроорганизмов, связанных с пластиком, все еще находится на ранних стадиях. Многие вопросы, касающиеся этих экологических ниш, остаются без ответа, и существуют ограничения в точной идентификации анализируемых штаммов на видовом уровне.

Комментарии закрыты.